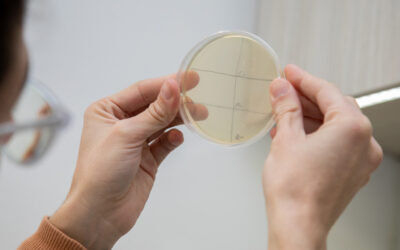
La UNAHUR financiará 15 proyectos en la Primera Convocatoria UNAHUR INTA “PID-UI 2026”

Sec. de Investigación
UNAHUR Investiga: Materiales educativos para fortalecer la enseñanza de la matemática en la escuela secundaria
La UNAHUR financiará 15 proyectos en la Primera Convocatoria UNAHUR INTA “PID-UI 2026”
La UNAHUR abre dos convocatorias permanentes para investigación en 2026
Conferencia sobre neurodegeneración y pasantías en el Max Planck de Rosario: la UNAHUR impulsa la formación científica
UNAHUR Investiga: Nanopartículas de oro para tratar una enfermedad tropical desatendida
UNAHUR Investiga: El desarrollo informático para el análisis automático de imágenes satelitales
Científicos argentinos descubren que el cannabis puede eliminar bacterias que causan más de 700 mil muertes por año
Primera Convocatoria a Proyectos de Investigación y Desarrollo UNAHUR INTA “PID-UI 2026”
UNAHUR Investiga: Alimentos funcionales a partir del kéfir
La Provincia de Buenos Aires financiará cuatro proyectos de la Unahur
V Encuentro Argentino de Cuerpos Finitos y Temas Afines
Estudiantes
Investigadores
Carreras
Inscriptos en talleres de extensión
Contactanos
CENTRO INTEGRAL DE ATENCIÓN AL ESTUDIANTE:
Atención de lunes a viernes de 10 a 19hs
Comunicate con:
gestionestudiantil@unahur.edu.ar